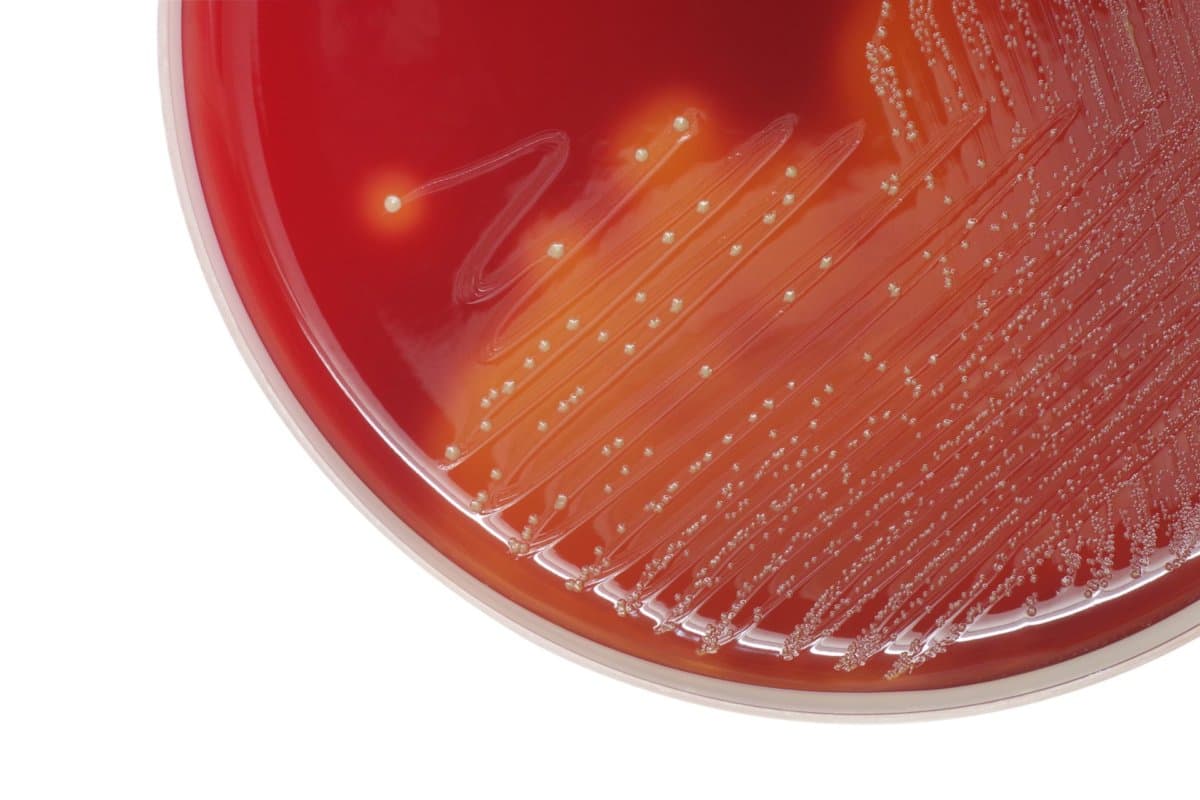

Mehr invasive Gruppe-A-Streptokokkenerkrankungen (iGAS) bei Kindern – woran liegt das?
In den letzten beiden Jahren wurde eine Zunahme von Fällen invasiver Gruppe-A-Streptokokken (iGAS) bei Kindern beobachtet. Dies könnte auf eine erhöhte Prävalenz von Viruserkrankungen wie Varicella zoster zurückzuführen sein, die Streptokokken-Infektionen begünstigen.
Laut PD Dr. Christian Kahlert, Leitender Arzt für Infektiologie & Spitalhygiene am Ostschweizer Kinderspital St. Gallen, hat sich aufgrund der Corona-Pandemie die Dynamik einiger Infektionskrankheiten verändert (1).
Ein Beispiel dafür sind Infektionen mit dem Respiratory Syncytial Virus (RSV), die normalerweise im Herbst und Winter auftreten. Nach Aufhebung der Infektionsschutzmassnahmen beschäftigten sie plötzlich auch im Sommer in ungewöhnlich hoher Zahl die pädiatrischen Stationen.
Auffälliger Anstieg bei iGAS
Überrascht war man zuletzt aber auch ob der Häufigkeit invasiver Infektionen mit dem Bakterium Streptococcus pyogenes (Gruppe-A-Streptokokken, GAS). Die europäische Infektionsüberwachungsbehörde ECDC und die WHO meldeten im Dezember 2022 etwa einen massiven Anstieg von iGAS-Fällen in fünf europäischen Ländern.
Auch das Schweizer Überwachungssystem für seltene pädiatrische Erkrankungen (SPSU) in registrierte zu diesem Zeitpunkt ungewöhnlich viele iGAS-Fälle. Während im Jahr 2019 44 Fälle bei Kindern unter 16 Jahren gemeldet wurden und im Jahr 2021 20 Fälle, stieg die Zahl im Jahr 2022 auf insgesamt 112. Dieser Trend setzte sich auch im Jahr 2023 fort, mit 223 iGAS-Fällen (2). Von November 2022 bis Ende März 2023 verstarben in der Schweiz insgesamt vier Kinder im Zusammenhang mit iGAS (3).
Gruppe-A-Streptokokken: Von Halsschmerzen bis Toxic-Shock-Syndrom
Streptokokken der Gruppe A (GAS) können eine Vielzahl von Erkrankungen verursachen. Am häufigsten äussern sie sich als bakteriell bedingte Pharyngitiden oder Scharlach.
In seltenen Fällen könnten GAS invasive Infektionen (iGAS) verursachen, die sich als Bakteriämien, Lungenentzündungen, oder Haut- bzw. Knocheninfektionen (Zellulitis, Osteomyelitis, nekrotisierende Fasziitis) manifestieren. Bei ihnen kann das Bakterium in normalerweise sterilen Flüssigkeiten (Blut, Liquor, Pleurapunktat) nachgewiesen werden. Auch das toxische Schock-Syndrom (TSS) ist eine mögliche Ausprägung, die zu schweren Organveränderungen und Nekrosen führt.
iGAS sind derzeit für 0,3 bis 0,9 Prozent aller pädiatrischen Krankenhausaufenthalte verantwortlich. Die Gesamtmortalität liegt bei Kindern zwischen zwei und acht Prozent (bei Erwachsenen 10-15%).
Im Kindesalter stellen Risikofaktoren dar:
- das Säuglingsalter,
- Infektionen (z.B. mit Varicella zoster oder Influenza),
- Barrierestörungen (z.B. Verbrennungen oder chirurgische Eingriffe),
- Immunsuppression (durch Medikamente, Malignome oder angeborene Immundefekte) und
- die Einnahme bestimmter Medikamente (wie Kortikosteroide oder potenziell NSAR bei nekrotisierender Fasziitis)
Keine Hinweise auf erhöhte Invasivität
Ein mässiger Anstieg der iGAS-Fälle bei Erwachsenen wurde bereits seit 2014 registriert, erklärt PD Dr. Kahlert. Durch die Covid-Pandemiemassnahmen sanken diese Zahlen zunächst; nach ihrer Aufhebung stiegen allerdings sowohl die Zahlen der nichtinvasiven, als auch die der invasiven Gruppe-A-Streptokokkenfälle aber massiv an.
Als Grund für die vermehrte Ausbreitung von iGAS fahndeten Wissenschaftler unter anderem nach einer möglicherweise erhöhten Invasivität der Bakterienstämme. Es gibt jedoch bisher keine Hinweise darauf, dass der aktuell dominante Streptokokken-Stamm, der das M1-Gen trägt (das grundsätzlich nicht für eine signifikante Erhöhung der Invasivität bekannt ist) in irgend einer Form infektiöser ist. Und auch andere Faktoren, die die Virulenz erhöhen könnten, (z.B. eine verstärkte Produktion von Exotoxinen) wurden bisher nicht beobachtet.
Es gibt zudem keine Anzeichen darauf, dass sich iGAS-Fälle im Allgemeinen verschlimmert haben, etwa in Bezug auf die Einweisung auf die Intensivstation oder die Dauer der intensivmedizinischen Betreuung. Und auch die Häufigkeit von Organmanifestationen und Bakteriämien sowie die Empfindlichkeit gegenüber Beta-Lactam-Antibiotika, einschliesslich Penicillin, sind bisher unverändert, wie PD Dr. Kahlert betont.
iGAS als Passagier viraler Infekte
Am plausibelsten ist hingegen bisher die Annahme, dass eine verstärkte Viruszirkulation eine Rolle bei der Verbreitung von iGAS spielt. Seit der Aufhebung der Massnahmen gegen Covid-19 sind etwa Fälle von Atemwegserkrankungen (z.B. mit RSV, Varizellen, Enteroviren und Influenza) wieder stark angestiegen.
Und da virale Infektionen oft als Eintrittspforte für invasive Streptokokken-Infektionen dienen, finden diese derzeit günstige Verhältnisse vor.
Mit der neu im Schweizer Impfplan verankerten Impfung gegen VZV hofft man, dass auch die Infektionen mit invasiven Gruppe-A-Streptokokken zurückgehen werden, sagt PD Dr. Kahlert. Derzeit gehen etwa 15 bis 20 Prozent der iGAS-Fälle im Kindesalter auf das Konto von VZV-Infektionen.
Verlust der Streptokokken-Immunität unplausibel
Einen anderen Verdacht hält der Experte im übrigen nicht für plausibel: Nämlich, dass die vermehrten iGAS-Fälle auf einen Verlust der Immunität gegen Streptokokken zurückzuführen sind. Die Existenz einer Immunität gegen Streptokokken sei bisher noch wenig erforscht, und ob Antikörper gegen Streptokokken-Bestandteile überhaupt eine Schutzfunktion haben, noch nicht bekannt.
Wie oft werden iGAS im Haushalt übertragen?
Eine Übertragung einer invasiven Streptokokken-Infektion im Haushalt ist relativ unwahrscheinlich. Für enge Kontaktpersonen von iGAS-Patienten benötigt es laut einem Statement der pädiatrie Schweiz vom 31. März 2023 kein besonderes Management.
- Kahlert C. Nehmen invasive Gruppe A Streptokokkenerkrankungen im Kindesalter zu? WebUp Experten-Forum Update Infektiologie. 22. August 2023, online
- pädiatrie schweiz und Bundesamt für Gesundheit. Erfassung von seltenen pädiatrischen Erkrankungen bei in Spitälern behandelten Kindern. Swiss Paediatric Surveillance Unit (SPSU) 2023, Stand 4. Januar 2024, abgerufen am 5. Januar 2024
- Pediatric Infectious Disease Group of Switzerland. Invasive Infektionen mit Gruppe A Streptokokken (iGAS) bei Kindern. Update vom 31. März 2023 - Statement der PIGS. Abgerufen am 21.November 202
